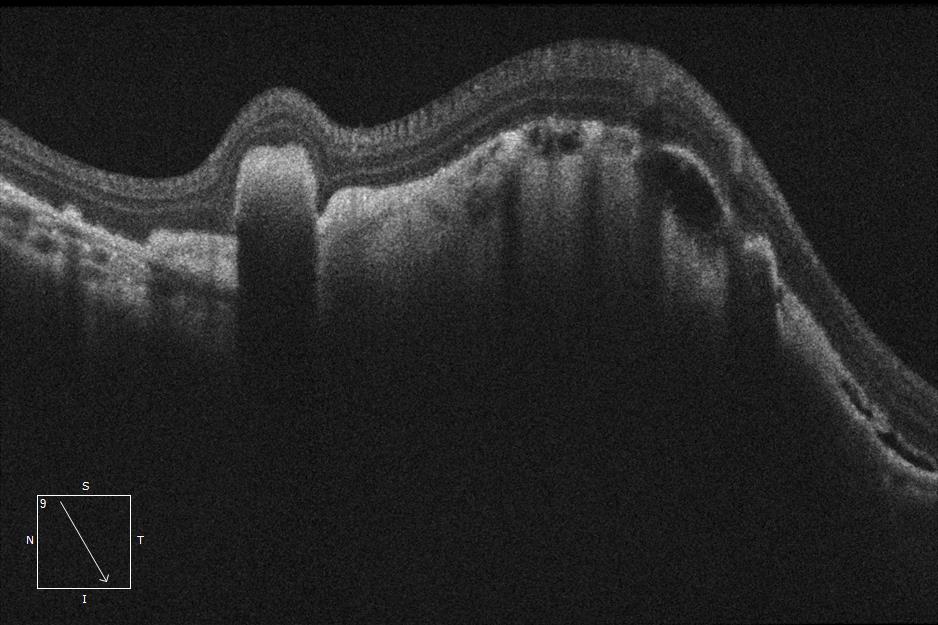
#PathologicalMyopia &amp; #CNV
Pictured by Apollo, the #ConfocalRetinalOphthalmoscope
#autofluorescence #fluorescenceangiography #funduscamera #retinaldiseases #Oct #laserscanning

Microclear Medical
@microcleartec
Focused on ophthalmology and optometry imaging, integrates self-developed core components with arti-intelligence and interactive technology and serve the world.
ID: 1442743379033419778
https://www.microcleartech.com/en/home 28-09-2021 06:51:14
76 Tweet
19 Takipçi
71 Takip Edilen